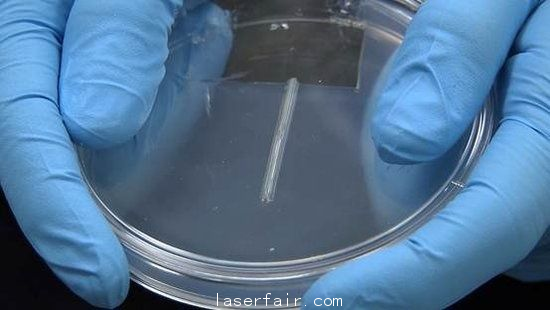

据外媒Computer World报道,美国生物科技公司Organovo日前透露,将于2014年年底推出3D打印的人体器官,通过“生物打印”技术,3D打印出完整的人类肝脏将成为现实。

3D打印人体肝脏明年问世
据悉,生物打印技术通过逐层堆叠的方式来构造物体,采用的基础材料为人体细胞。3D打印机将逐层打印肝脏细胞和血管内壁细胞,共打印约20层,这些细胞会形成一个坚实的实体器官,起到人体组织的作用。不过,创建人体组织最大的障碍是如何制造出为生命提供氧气和营养物质运输的血管系统,因为一旦脱离氧气和营养,活的细胞就会逐渐死亡。对此,Organovo公司表示已经克服了这一难题。
然而,只打印出单独的肝脏组织细胞并不能代表全部,只有将不同的细胞组织有机结合才能制造出一个活的人体器官。Organovo公司商业运营执行副总裁Mike Renard表示,“我们的技术人员能够将拥有微血管网络功能的纤维细胞与内皮细胞融合,制造出具有良好细胞生存能力、具有一定厚度的组织。”
据了解,Organovo公司打印出的肝脏暂时只用于科研和药物测试,并不用于实际的器官移植治疗。Mike Renard称,“目前来看,将打印的人体组织应用到医疗领域还为时尚早,这个过程只能通过持续的器官组织开发和临床试验来完成。此外,还要通过食品和药物管理局的评估,通常来说,这一过程至少需要三至十年。”
转载请注明出处。








 相关文章
相关文章
 热门资讯
热门资讯
 精彩导读
精彩导读





















 关注我们
关注我们




